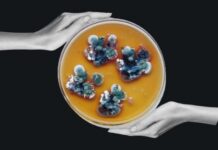
Загадочная чернобыльская плесень, которая «питается» радиацией: как ее можно использовать

Автор фото, Getty
Извержение вулкана около 1345 года могло спровоцировать цепочку событий, которые привели к смертельной пандемии в Европе – «Черной смерти», полагают ученые. Вулканическая активность вызвала климатическую катастрофу, которая, в свою очередь, привела к неурожаю.
Чтобы избежать голода, итальянским городам-государствам приходилось импортировать зерно из Причерноморья. Вместе с зерном они принесли в Европу блох-переносчиков болезней.
«Идеальный шторм» климатических потрясений, голода и международной торговли в Средние века является напоминанием о том, как болезни могут возникать и распространяться в глобализованном (и более теплом) мире, говорят эксперты.
«Конечно, сочетание факторов, приведших к эпидемии чумы, кажется редким. Но в условиях изменения климата, в глобализированном мире, вероятность новых зоонозных заболеваний (передаваемых человеку от животных — Ред.) заболеваний, которые затем могут перерасти в пандемию», — говорит доктор Ульф Бюнтген из Кембриджского университета.
«Это особенно актуально сейчас, учитывая наш недавний опыт борьбы с COVID-19», — добавляет он.

Автор фото, Фото: Ульф Бюнтген
«Чёрная смерть» — эпидемия бубонной чумы — унесла жизни, по некоторым оценкам, до половины населения Европы в 1348-1349 годах.

Фото предоставлено Getty
Заболевание вызывается бактерией Yersinia pestis, которую переносят грызуны (например, крысы) и блохи.
Ученые полагают, что эпидемия началась в Средней Азии и благодаря торговле распространилась на Европу.
Однако точная последовательность событий учёным была неизвестна.
Теперь исследователи из Кембриджского университета и Института восточноевропейской истории и культуры Лейбница в Лейпциге заполнили пробелы в этой картине.
Они изучали годичные кольца и ледяные керны (образцы льда, часто используемые для изучения изменения климата), чтобы понять, какими были климатические условия во время эпидемий чумы.
Имеющиеся данные свидетельствуют о том, что около 1345 года вулканическая активность вызвала значительное падение температуры на несколько лет вперед из-за пепла и газов, блокирующих солнечный свет.
Это, в свою очередь, привело к плохим урожаям в Средиземноморском регионе. Чтобы избежать голода, итальянские города-государства начали покупать зерно у торговцев из Черноморского региона, тем самым позволив смертельным бактериям закрепиться в Европе.

Историк Мартин Баух, эксперт по средневековому климату и эпидемиологии в Институте Лейбница, говорит, что сочетание климатических явлений и сложной системы снабжения продовольствием привело к «идеальному шторму».
«Более ста лет влиятельные итальянские города торговали между Средиземноморьем и Черным морем. Морские регионы, что позволило им быстро принять меры, когда нависла угроза голода», — говорит он.
«Но в результате эти меры привели к куда более страшной катастрофе», — заключил учёный.
Результаты исследования были опубликованы в журнале Communications Earth & Environment.